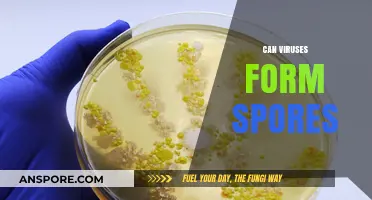
Do Viruses Form Spores? Unraveling the Survival Strategies of Microbes

The presence of mold spores in the lungs is a concerning issue that can arise from prolonged exposure to mold-infested environments. These microscopic particles can be inhaled, potentially leading to respiratory problems and other health complications, especially in individuals with pre-existing conditions or weakened immune systems. While the body's natural defenses can often cope with low levels of mold spores, high concentrations or chronic exposure may overwhelm these mechanisms, necessitating medical intervention. Understanding the risks associated with mold spores in the lungs and exploring effective methods to mitigate their impact is crucial for maintaining respiratory health and overall well-being.
Explore related products
$18.66 $26.99
What You'll Learn

Symptoms of mole spore infection in lungs
Mole spores in the lungs, though rare, can lead to a condition known as pulmonary histoplasmosis, caused by the fungus *Histoplasma capsulatum*. This infection often mimics other respiratory illnesses, making it crucial to recognize its unique symptoms. Early detection is key, as untreated cases can progress to severe complications, particularly in immunocompromised individuals. Understanding the signs can prompt timely medical intervention, potentially preventing long-term damage.
Symptoms typically appear 3–17 days after exposure and vary widely in severity. Mild cases may present as flu-like symptoms, including fever, chills, headache, and muscle aches. Persistent dry cough and chest discomfort are also common, often mistaken for a common cold or bronchitis. In more severe cases, especially in those with weakened immune systems, symptoms can escalate to include weight loss, chronic cough, and difficulty breathing. High-risk groups, such as HIV/AIDS patients or organ transplant recipients, may experience disseminated histoplasmosis, where the infection spreads beyond the lungs, affecting organs like the liver, spleen, or adrenal glands.
Children and older adults are particularly vulnerable to misdiagnosis due to the nonspecific nature of early symptoms. For instance, infants exposed to high concentrations of spores may develop acute pulmonary histoplasmosis, characterized by high fever, cough, and respiratory distress. In contrast, older adults might exhibit more subtle signs, such as fatigue or mild fever, which can be overlooked. Monitoring for persistent or worsening symptoms is essential, especially if there’s a known exposure to environments like caves, bird roosts, or soil enriched with bird or bat droppings, where the fungus thrives.
Diagnosis often involves a combination of chest X-rays, blood tests, and sputum cultures to confirm the presence of the fungus. Treatment depends on the severity of the infection. Mild cases may resolve on their own without medication, but severe or disseminated infections require antifungal therapy, such as itraconazole or amphotericin B. Dosage and duration vary—itraconazole is typically prescribed at 200–400 mg daily for 6–12 weeks, while amphotericin B is administered intravenously for more critical cases. Prevention is equally important; avoiding dusty environments and wearing masks during activities like gardening or construction in endemic areas can reduce exposure risk.
In summary, recognizing the symptoms of mole spore infection in the lungs is critical for early intervention. From flu-like manifestations to severe respiratory distress, the presentation can vary widely, particularly in vulnerable populations. Timely diagnosis and appropriate treatment, coupled with preventive measures, can effectively manage this condition and prevent complications. Awareness and proactive monitoring are the first lines of defense against this often-overlooked fungal infection.
Seeds vs. Spores: Unveiling the Unique Differences in Plant Reproduction
You may want to see also

Treatment options for lung mole spores
Mole spores in the lungs, though rare, present a unique challenge due to their resilience and potential health risks. Treatment options must address both the fungal nature of the spores and their deep-seated location within the respiratory system. The first line of defense typically involves antifungal medications, which are tailored to the specific type of mold identified through diagnostic testing. Common antifungal agents such as itraconazole, voriconazole, or amphotericin B are prescribed, with dosages ranging from 200 to 400 mg daily for adults, depending on the severity of the infection and the patient’s overall health. Pediatric dosages are weight-adjusted, typically starting at 5 mg/kg/day, under strict medical supervision.
Beyond medication, the effectiveness of treatment often hinges on the patient’s immune response. Immunocompromised individuals, such as those with HIV/AIDS, organ transplant recipients, or patients undergoing chemotherapy, require more aggressive and prolonged therapy. In some cases, combination therapy—using two or more antifungal drugs simultaneously—may be necessary to combat resistant strains. Additionally, adjunctive measures like pulmonary physiotherapy can help clear fungal debris from the lungs, improving respiratory function and reducing the risk of complications like bronchial obstruction.
A comparative analysis of treatment approaches reveals that surgical intervention is rarely the first choice but may become necessary in severe cases. For instance, if mold spores form large masses (aspergillomas) within the lung cavities, surgical resection might be required to prevent hemorrhage or chronic infection. However, surgery carries significant risks, particularly in patients with pre-existing lung conditions, making it a last resort. Non-invasive methods, such as bronchoscopic debridement, offer a less risky alternative by physically removing fungal material through a scope inserted into the airways.
Persuasively, prevention remains the most effective strategy for managing lung mold spores. Reducing exposure to mold-prone environments, such as damp buildings or areas with high organic debris, is critical. For those at high risk, regular monitoring of indoor air quality and the use of HEPA filters can significantly lower spore inhalation. In healthcare settings, early detection through routine chest imaging and fungal serology tests can preemptively address infections before they become systemic.
In conclusion, treating lung mold spores requires a multifaceted approach that combines targeted antifungal therapy, immune support, and, in extreme cases, surgical intervention. Practical tips include adhering strictly to medication regimens, maintaining a mold-free living environment, and seeking prompt medical attention for respiratory symptoms. While challenging, successful treatment is achievable with early intervention and comprehensive care.
Are Green Mold Spores Dangerous? Understanding Health Risks and Safety Tips
You may want to see also

Preventing mole spore exposure in lungs
Mole spores, though not a widely recognized health threat, can pose risks when inhaled, particularly for individuals with compromised immune systems or respiratory conditions. Preventing exposure to these spores in the lungs begins with understanding their sources and behaviors. Moles themselves are not harmful, but their burrowing activities can disturb soil and organic matter, releasing spores from fungi and molds into the air. These spores, when inhaled, can settle in the lungs and potentially cause infections or allergic reactions. Awareness of environments prone to mole activity—such as gardens, lawns, or agricultural fields—is the first step in minimizing exposure.
To effectively prevent mole spore inhalation, practical measures must be implemented during outdoor activities. Wearing a mask, particularly one rated N95 or higher, can filter out microscopic spores when working in areas where moles are active. For individuals with prolonged exposure risks, such as gardeners or farmers, investing in a respirator with replaceable filters offers enhanced protection. Additionally, maintaining good ventilation in indoor spaces adjacent to mole-prone areas can reduce the accumulation of airborne spores. Simple actions like keeping windows closed during peak mole activity seasons and using air purifiers with HEPA filters can significantly lower indoor spore concentrations.
Children and the elderly, whose immune systems may be less robust, require special consideration in preventing mole spore exposure. For children playing outdoors, designate play areas away from molehills or freshly tilled soil, where spore concentrations are highest. Encourage handwashing after outdoor activities to prevent accidental ingestion of spores. For the elderly, particularly those with pre-existing respiratory conditions like COPD or asthma, avoiding direct contact with soil and wearing protective gear during outdoor tasks is crucial. Regular monitoring of indoor humidity levels—ideally below 50%—can also inhibit mold growth, reducing the overall spore load in living spaces.
Comparatively, preventing mole spore exposure shares similarities with mitigating other airborne contaminants, such as pollen or dust. However, the localized nature of mole activity allows for targeted interventions. For instance, installing physical barriers like mesh screens over garden beds can deter moles while minimizing soil disturbance. Unlike broader environmental allergens, mole spores can be controlled at the source by addressing the root cause—mole infestations. Employing humane mole deterrents, such as vibrating stakes or castor oil-based repellents, can reduce burrowing activity and, consequently, spore release. This proactive approach not only protects lung health but also preserves the ecological balance of outdoor spaces.
In conclusion, preventing mole spore exposure in the lungs requires a combination of awareness, protective measures, and targeted interventions. By understanding the link between mole activity and spore release, individuals can adopt practical strategies to minimize inhalation risks. From wearing protective gear to modifying outdoor environments, these steps empower people to safeguard their respiratory health without compromising their connection to nature. Whether for personal well-being or the protection of vulnerable family members, these measures offer a tangible way to address a lesser-known but preventable health concern.
Mildew Spores in Your Home: Uncovering the Link to Hair Loss
You may want to see also
Explore related products

Diagnosis methods for lung mole spores
Mole spores in the lungs, though rare, can present a diagnostic challenge due to their nonspecific symptoms, which often mimic more common respiratory conditions. Early and accurate diagnosis is crucial for effective treatment, making it essential to understand the methods available for identifying these spores. The first step typically involves a thorough medical history and physical examination, focusing on symptoms such as persistent cough, shortness of breath, chest pain, and unexplained weight loss. Patients with a history of environmental exposure to mold or compromised immune systems are at higher risk and should be prioritized for further evaluation.
Imaging studies play a pivotal role in diagnosing lung mole spores. A chest X-ray or CT scan can reveal characteristic findings such as nodules, cavities, or infiltrates, which may suggest fungal infection. However, these findings are not exclusive to mole spores and can overlap with other conditions like tuberculosis or lung cancer. For this reason, radiological results must be interpreted in conjunction with clinical symptoms and additional diagnostic tests. High-resolution CT scans are particularly useful for identifying the extent and pattern of lung involvement, guiding subsequent interventions.
Microbiological confirmation is the gold standard for diagnosing mole spores in the lungs. Sputum cultures, bronchoalveolar lavage (BAL), or tissue biopsies can be analyzed to isolate and identify the fungal pathogen. Molecular techniques, such as polymerase chain reaction (PCR), offer rapid and sensitive detection of fungal DNA, even in cases where traditional cultures yield negative results. For patients unable to produce sputum, induced sputum or bronchoscopy with BAL may be necessary. It’s critical to handle samples carefully to avoid contamination, as false positives can lead to inappropriate treatment.
Serological tests, which detect antibodies or antigens specific to the fungus, provide an additional diagnostic tool, particularly in immunocompromised patients. Blood tests for fungal antigens, such as galactomannan or (1→3)-β-D-glucan, can support the diagnosis but are not definitive on their own. These tests are often used in conjunction with imaging and microbiological methods to strengthen the diagnostic accuracy. However, their sensitivity and specificity vary depending on the fungal species and the patient’s immune status, underscoring the need for a multifaceted approach.
Finally, clinical judgment remains indispensable in diagnosing lung mole spores. A high index of suspicion, especially in at-risk populations, can expedite the diagnostic process. Collaboration between pulmonologists, infectious disease specialists, and radiologists ensures a comprehensive evaluation. Early diagnosis not only improves treatment outcomes but also prevents complications such as chronic pulmonary fibrosis or systemic dissemination. Patients should be educated about the importance of adhering to diagnostic procedures and follow-up care to manage this potentially serious condition effectively.
Can Mold Spores Stick to Your Skin? Uncovering the Truth
You may want to see also

Long-term effects of untreated lung mole spores
Untreated lung mole spores, though rare, can lead to severe and irreversible complications over time. These spores, often associated with fungal infections like histoplasmosis or coccidioidomycosis, may initially present as mild respiratory symptoms but can progress to chronic conditions if ignored. For instance, histoplasmosis, caused by the fungus *Histoplasma capsulatum*, can disseminate from the lungs to other organs, particularly in immunocompromised individuals. Without intervention, this can result in conditions such as fibrosing mediastinitis, a life-threatening complication where scar tissue forms around vital structures in the chest. Early detection and treatment are critical to prevent such outcomes, especially in high-risk groups like HIV/AIDS patients or organ transplant recipients.
The long-term effects of untreated lung mole spores often manifest as persistent respiratory issues, such as chronic cough, shortness of breath, and recurrent lung infections. Over time, these symptoms can lead to reduced lung function, measured by a decline in forced expiratory volume (FEV1) of 10–20% annually in severe cases. This deterioration is comparable to chronic obstructive pulmonary disease (COPD) and can significantly impair quality of life. For example, a 45-year-old individual with untreated histoplasmosis may experience progressive fibrosis, requiring supplemental oxygen within 5–10 years. Practical steps to mitigate this include regular pulmonary function tests and chest imaging for those living in endemic areas like the Ohio and Mississippi River valleys.
From a persuasive standpoint, ignoring lung mole spores is akin to neglecting a small crack in a foundation—it may seem insignificant initially but can lead to structural collapse. Fungal spores, once established, can form granulomas or cavities in the lungs, which may rupture and cause hemoptysis (coughing up blood). In children under 10, untreated infections can stunt lung development, leading to lifelong respiratory limitations. Adults over 65 face heightened risks due to age-related immune decline, making prompt antifungal therapy essential. Medications like itraconazole or amphotericin B, tailored to the specific fungal species, can halt progression and prevent complications like pulmonary hypertension, which occurs in 5–10% of untreated cases.
Comparatively, the long-term effects of untreated lung mole spores differ from bacterial pneumonia, which typically resolves with antibiotics. Fungal infections often require months of treatment and may relapse if therapy is incomplete. For instance, coccidioidomycosis (Valley Fever) can lead to chronic meningitis if spores disseminate to the brain, a complication seen in 1–5% of untreated cases. Unlike viral infections, which the immune system often clears, fungal spores can remain dormant and reactivate under stress or immunosuppression. This underscores the need for proactive management, including environmental precautions like avoiding dusty areas in endemic regions and using N95 masks during outdoor activities.
Descriptively, the lungs of someone with untreated mole spores resemble a landscape scarred by erosion—cavities, nodules, and fibrotic tissue replace healthy alveoli. Over decades, this can lead to cor pulmonale, a condition where the right side of the heart fails due to increased lung pressure. Patients may describe a relentless decline, from occasional breathlessness to constant fatigue and weight loss. For instance, a 50-year-old farmer with untreated coccidioidomycosis might progress from mild fever to requiring a lung transplant within 15 years. Preventive measures, such as antifungal prophylaxis for high-risk individuals and early imaging to detect granulomas, can avert this trajectory. In essence, untreated lung mole spores are not just a fleeting infection but a ticking clock that demands immediate attention.
Botulism Spores: Can They Cause Illness and Health Risks?
You may want to see also
Frequently asked questions
Mole spores do not exist, as moles are mammals and do not produce spores. Lung infections are typically caused by bacteria, viruses, fungi, or parasites, not by any organism related to moles.
If you suspect you’ve inhaled harmful spores (e.g., mold or fungal spores), seek medical attention. Treatment may include antifungal medications, corticosteroids, or other therapies prescribed by a healthcare professional.
There are no proven home remedies to remove spores from the lungs. Medical evaluation and treatment are essential for addressing respiratory infections caused by spores. Breathing clean air and avoiding exposure to mold or fungi can help prevent further issues.